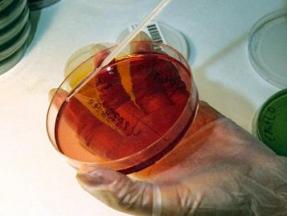

-
Tuesday, 11/03/2009
Leading Organizations Join Forces to Launch First Annual World Pneumonia Day, Fight World’s Leading Child Killer
WHO and UNICEF Release Global Action Plan to Combat Pneumonia as Part of Historic Effort
Dr. Antoni Torres, Head of Pneumology Department at the Hospital Clinic of Barcelona and Research team leader of the group Applied Research in Respiratory Diseases, says: “There are preventive and treatment strategies easy to implement that could prevent the deaths of many children”
-
Wednesday, 10/28/2009
European Society of Intensive Care Medicine Annual Congress focused on Influenza A (H1N1)

The results of two studies on Influenza A (H1N1) were presented at the Congress
Characteristics, treatment, and outcomes of critically ill patients in Canada and Australia with 2009 influenza A(H1N1) infection were presented at the latest European Society of Intensive Care Medicine Annual Congress, concurrently with early publications in the Journal of American Medical Association (JAMA 2009 Oct 12 Epub Ahead of Print).
-
Monday, 10/26/2009
Roundtable to discuss strategies for prevention of ventilator associated pneumonia
The session is open to specialized staff in intensive care and will take place in the classroom 11 of the Faculty of Medicine from 17.00 to 19.00 on Tuesday 27 October 2009
The group Applied Research in Respiratory Diseases (IAMR) has organized a meeting with the support of COVIDIEN addressed to intensive care staff to put on the table the most controversial aspects of mechanical ventilation-associated pneumonia (VAP) and innovative strategies to prevent it.
-
Thursday, 10/22/2009
Mariano Esperatti and Cristina Esquinas presented their work at the II CIBERES Training Meeting in Mallorca

More than 70 young researchers from Spain attended the Meeting and they had the chance to share both their experiences and the national and international studies that they are carrying out
Research physician Mariano Esperatti gave a lecture and research nurse Cristina Esquinas presented a poster session at the II CIBERES (Ciber de Enfermedades Respiratorias) Training Meeting on Respiratory Diseases that was held in Mallorca last 15-16 October.
-
Saturday, 10/17/2009
Hospital Clinic heads the ranking of screenings in the second phase of MOSAR surgical
Dr. Antonio Martínez and Encarna Moreno explained their experience to the other participating centres in MOSAR study
The amount of screenings done in Hospital Clinic exceeds 60%, which is believed to be the minimum percentage in order to obtain significant results. This is the reason why both Dr. Antonio Martínez and research nurse Encarna Moreno held a teleconference in which they described their experience to the other participating centres in the MOSAR study. In Martínez’s opinion, the key to this success is down to the involvement not only from medical assistants but also from research nurses, whose task is to supervise and help collecting samples.
-
Saturday, 10/10/2009
Many biomedical research projects might stop due to the current crisis

Ciberes budget cut will weaken the stability of research staff
The current economic crisis has an impact on all fields of society. To this respect, next 2010 Spain government’s Budget is to reduce public spending on research up to 18%, which will lead, in turn, to a Ciberes (Centro de Investigación Biomédica en Red, Enfermedades Respiratorias) budget cut up to 35,8%. Not only will this weaken the stability of research staff, but might also stop a lot of biomedical research projects.
-
Tuesday, 10/06/2009
Gianluigi Li Bassi will be awarded by next European Society of Intensive Care Medicine Annual Congress

The event will be held in Vienna next 11-14 October
Our research physician Gianluigi Li Bassi will attend the 22nd ESICM Annual Congress "Patient safety & quality of care in ICM", which will be held in Vienna next 11-14 of October 2009, in order to receive his award for the project on effects of inverse ratio ventilation on mucus clearance.
-
Monday, 10/05/2009
Cristina Esquinas is interviewed by “Publicación Médica de Neumología” on community-acquired pneumonia (CAP) and tobacco

The study involves 2.026 patients who were admitted due to CAP between 2002 and 2007
Cristina Esquinas presented her work at the 42th SEPAR’s National Congress. The aim of her research is to know if regular smoking has any influence on CAP. “We had a great database of community-acquired pneumonia. Besides, I work myself in a smoking cessation outpatient visit, so we had enough means and experience to carry out the study”, says Cristina Esquinas.
-
Sunday, 09/13/2009
Catia Cillóniz has been granted ERS Young Scientist Sponsorship to attend the European Respiratory Society Annual Congress
She will present the results of her research regarding the study of etiologic agents involved in community-acquired pneumonia. Doctors Antoni Torres, Miquel Ferrer, Néstor Soler, Jacob Sellarés and Eva Polverino participate in the event as well
Doctoral Researcher Catia Cillóniz has attended the ERS 2009 held in Viena thanks to the ERS Young Scientist Sponsorship she has been granted as an author of one of the best abstracts regarding the study of etiologic agents involved in community-acquired pneumonia and their relationship with population factors, which is the subject of her doctoral thesis.
-
Tuesday, 09/08/2009
Laia Fernández has been assigned an ESCMID Grant to participate in the first European Congress on Microbial Biofilms held in Rome
She has presented the results of her research, based on the microbiological and microscopic analysis of biofilm in endotracheal tubes in pigs
Doctoral Researcher Laia Fernández has been assigned the ESCMID Grant which allowed her to attend Eurobiofilms 2009, the first European Congress on Microbial Biofilms held in Rome on September 2-5, where she presented a poster session entitled Biofilm-Based Medical-Device-Related Infections.









